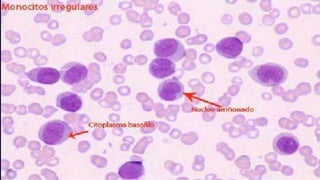

Este documento describe la leucemia mieloide aguda (LMA), incluyendo sus cuatro subtipos principales, etiología, fisiopatología, síntomas, diagnóstico y tratamiento. Explica que la LMA comienza en la médula ósea y resulta de cambios en el ADN que causan un rápido crecimiento anormal de células. El tratamiento consiste en quimioterapia de inducción, consolidación y mantenimiento para lograr la remisión y prevenir recaídas.





![Fisiopatologia
Cada paciente puede desarrollar una variedad distinta de la enfermedad, a simple vista igual,
pero molecularmente diferente (Genetica)
LEUCEMOGENESIS
Origen o promoción (Mutaciones de los oncogenes) [Proliferación & apoptosis]
Expansión o proliferación (Crecimiento celular) [30 días]
Aparición clínica (Detección)
Se requiere de 2 a 6 meses & la cantidad de “blastos” es de 1X10₁₂ (1kg de tejido)
LEUKEMIA & LYMPHOMA SOCIETY ®; 2014](https://image.slidesharecdn.com/leucemiamieloideaguda-150824181256-lva1-app6892/85/Leucemia-mieloide-aguda-6-320.jpg)